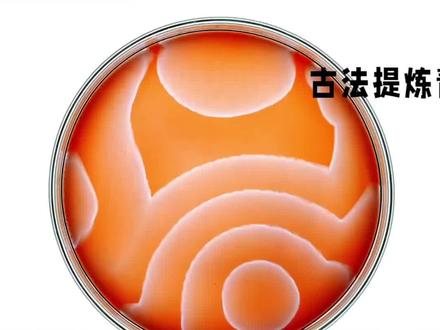
穿越必备技能,古法制作青霉素!

古法青霉素怎么使用
粉丝1.2万获赞39.5万
相关视频
 01:41
01:41 01:41
01:41 01:58
01:58 01:20查看AI文稿AI文稿
01:20查看AI文稿AI文稿你知道吗?中国人竟然在五六百年前就开始使用青霉素治病了。在一九二八年的时候,英国人亚历山大佛来民在一个极为偶然的情况下发现了青霉素,但是当时的青霉素制造非常困难,所以也就导致了其价格非常的昂贵,堪比黄金。 不过早在明朝时,就有这样一种神药,就被当时的各大寺院广泛地用来治病救人。一九三七年日本占领上海后,也曾特意跑到常州天宁寺去抢夺这些神药。为什么日本人会跑到寺庙去抢夺神药呢?因为这款神药的最初运用就是在天宁寺 时的僧人会搜集大量的芥菜,用一个个的大缸将他们装起来,然后天天日晒夜露,使得芥菜没变,直到长出十几厘米的绿色青梅。紧接着再将这些大缸完全密封,埋入地下,最少也要经过十年光阴的沉淀才能开缸。此时缸内的芥菜早已完全 化成了水,之前的青梅也早已消失不见,而这水就是传说中的臣妾菜鲁。据纲目十一记载,臣妾菜鲁为贤性,良露肺经,能下痰,清热定咳,治肺庸喘胀,用陈酒,色如泉水缓虾治。本草会言更是这样记载,道,治肺庸吐脓血,咳嗽面肿。 陈年芥菜卤酒埋地中者,每日取食数迟,温汤炖热饮之。陈芥菜卤,这一个治疗肺部、咽喉部疾病的良药,就是我们最早发明的青霉素。
3521传承郭生白中医文化 01:08查看AI文稿AI文稿
01:08查看AI文稿AI文稿这个青霉素啊,家家都有,人人都用,不管是兽用的还是人用的都可以啊,接下来就分享一下这个青霉素的几个用法啊。第一点就是如果说猪不吃食,可以使用这个双黄连吸食青霉素给主打。第二个呢就是这个猪拉稀啊,你可以用这个氢钠霉素吸食这个青霉素给主打。 第三点就是这个猪单独身上有圆形的或者菱形的凸起的肿块,这种情况下呢,你可以用柴胡兑青霉素给主打,上午一次,下午一次就可以了。 第四点就是如果说这个猪啊得了皮肤病了,咱们可以用那个青霉素混合蒂塞米松,再混合咱们食用的那个食用油啊,一起给猪涂抹全身,上午用一次,下午用一次就可以了。 然后啊第五点就是这个猪啊,腿疼腿贴不敢着地,这种情况下呢,可以使用这个青霉素加上这个第三米松,加上这个安通腚啊,给猪打就可以了。 最后一点啊,就是猪清宫的时候,假如说咱家的母猪有子宫内膜炎,这个时候啊就需要清宫了,可以用这个生理盐水啊,怼上这个青霉素啊,加上两只链霉素,再兑上两只这个寿宫素混合在一起,呃,摇匀以后啊,给猪进行清宫就可以了。这个呢就是青霉素的几个用法,有需要的朋友啊,可以收藏。
1725岳岳养殖 08:41查看AI文稿AI文稿
08:41查看AI文稿AI文稿位置又已被其自身已摆好,首先已开启的游戏内可以使用。房间安全安静,卧室度适宜,光线充足,服务色标要求, 戴口罩, 核对六床王丽君号二零二三零二二四专一主机银青霉素陪食液配置两百单位每毫升双人核对五五 青霉素八十万单位在牙漆内 p 号 h 一三零二零六五七瓶口完整,瓶身瓶底无裂纹,粉末多关检查粉末均 零,松散无级金木超级可以使用。 开启瓶口百分之零点九零化钠溶液十毫升在牙齿内 溶液对光检查,溶液澄清无浑浊,无沉淀,无絮状物,可以使用。 明确包装好在遥期内加 o o t 可以使用。酒精已开启,在遥期内可以使用二点 已开启的新内部使用。 消毒晒干, 第二次消毒, 拜拜 消毒带干五金储物前代而期内花儿值胶带也变色,只卡一变色。铜红金刚内裙纱布花值胶带也变色,只卡一变色 五毫升自由器在期内 p r voc 可以使用。 悬肩紧密,刻度清晰,震动完整,回抽无漏气,可以使用。 针头间转到风力无勾无弯曲。 百分之零点九氯化钠溶液十毫升, 抽四毫升溶液 排气 青霉素八十万单位注入四毫升溶液, 摇晃 抽四毫升空气, 你好,是热气的器内加热气可以使用。 悬肩紧密,刻度清晰,针筒完整,回抽不漏气,可以使用 这种坚持的风力无过无关区可以使用。抽零点一毫升空气 青霉素注入零点一毫升空气,抽零点一毫升溶液 那个 百分之零九滴花量溶液十二升, 冲零点九毫升溶液 排气 推至零点一毫升 二抽。 对呀啊 排气 推至零点一毫升三抽 yi 配置成功, 再次核对六床王立二零二三零二二四青霉素脾食液配置 首先已开启 ps 内 啊啊 摘口罩记录 操作完毕。
9111曼曼学护理操作
猜你喜欢
- 3.7万老树怪谈













